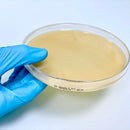
Mueller Hinton II Agar

Descrizione
Terreno per il test di sensibilità agli antimicrobici dei comuni micro- organismi aerobi a crescita rapida, mediante la tecnica di diffu- sione su dischetto (metodo Kirby-Bauer), come standardizzato dal Clinical and Laboratory Standards Institute (CLSI) e dal European
Committee on Antimicrobial Susceptibility Testing (EUCAST).
10 pz (140mm)
Codice: 10231
Pagamenti sicuri con
Le tue informazioni di pagamento sono trattate in sicurezza. I dettagli della tua carta non verranno conservati.